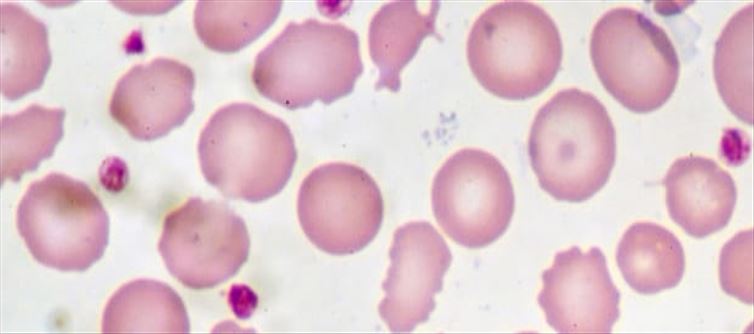
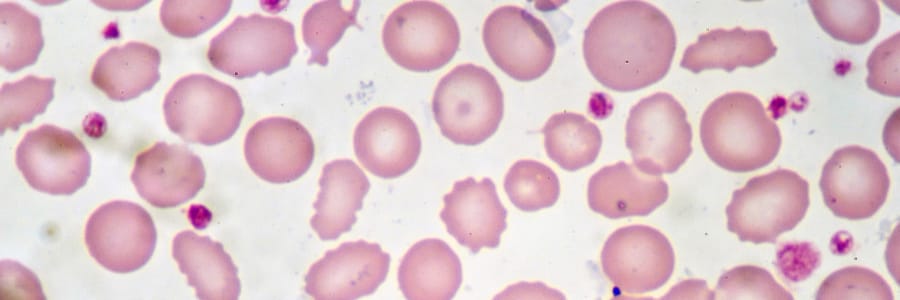

The world's most expensive drug has hit the market. Recently, the FDA of America has given the stamp of approval to use this drug in connection with a rare disease. It is in this background that a leading pharmaceutical company from australia has recently brought that drug to the world market. How much is this drug?.. To know what disease it is used for, you have to read this article completely..!
.jpeg)
Hemophilia B is caused by blood clotting problems. Scientists have previously identified that this problem is caused by a deficiency of factor 9 (ix), a protein produced in the liver. For the last few years research has been done to prevent this problem. Finally, the leading pharmaceutical company 'CSL Limited' of australia has found a solution for the rare disease Hemophilia B.

Recently, CSL Limited brought the drug 'Himefilio B' into the market after the FDA approved it. The price of this drug is currently set at 3.5 million dollars. Its value in indian currency is 28.61 crores. Its value is huge compared to the drugs available in the market till now. This made 'Hemophilia B' drug the most expensive drug in the world.One in every 40 thousand people suffer from hemophilia B. Many organizations are already offering various treatments for this rare disease. But now the medicine brought by CSL will be effective for a long time. This hemophilia drug treatment involves a genetically modified virus that injects a special substance into the liver.
CSL Company states that by this factor 9 (ix) is released from the liver. This company is marketing two types of drugs in the US market under the name of 'Hemogenics'. One of them is worth 2.8 million dollars and the other is worth 3 million dollars. CSL said that they are making all kinds of arrangements to make these medicines available all over the world soon.
CSL Company states that by this factor 9 (ix) is released from the liver. This company is marketing two types of drugs in the US market under the name of 'Hemogenics'. One of them is worth 2.8 million dollars and the other is worth 3 million dollars. CSL said that they are making all kinds of arrangements to make these medicines available all over the world soon.




 click and follow Indiaherald WhatsApp channel
click and follow Indiaherald WhatsApp channel